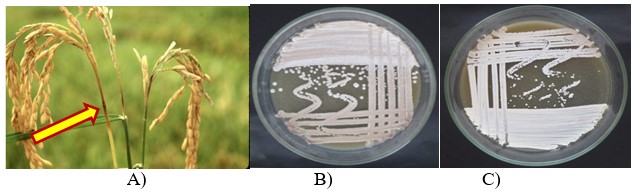

Tìm kiếm giải pháp sinh học để điều trị bệnh đạo ôn
Bệnh đạo ôn do nấm Pyricularia oryzae (P. oryzae) gây ra là 1 trong 3 loại bệnh chủ yếu ảnh hưởng lớn đến năng suất và chất lượng lúa trên phạm vi toàn thế giới. Bệnh do nấm P. oryzae tấn công trên tất cả các bộ phận của cây lúa, gây thiệt hại lên đến hàng trăm triệu tấn lúa mỗi năm. Tại Bạc Liêu, bệnh đạo ôn gây thiệt hại trên diện rộng ở khắp các mùa vụ với nhiều mức độ khác nhau. Đặc biệt, ở các ruộng nhiễm mặn canh tác lúa tôm, bệnh đạo ôn xuất hiện gây hại tương đối sớm và lan nhanh nếu không phun thuốc kịp thời. Trong khi đó, việc sử dụng thuốc hoá học cũng ảnh hưởng ít nhiều đến tôm càng xanh nuôi trong ruộng lúa và vụ tôm luân canh tiếp theo. Với mục tiêu duy trì phát triển mô hình canh tác lúa - tôm hiệu quả và bền vững, thích ứng với biến đổi khí hậu, hướng đến sản xuất lúa và tôm an toàn, đạt tiêu chuẩn xuất khẩu, cần phải nghiên cứu tìm ra giải pháp sinh học để quản lý bệnh đạo ôn hiệu quả, tiến đến xây dựng quy trình quản lý tổng hợp bệnh đạo ôn hại lúa trong mô hình canh tác lúa tôm trên vùng đất nhiễm mặn.
Về biện pháp sinh học, việc nghiên cứu ứng dụng xạ khuẩn được xem là giải pháp đầy triển vọng và có nhiều tiềm năng thay thế thuốc hóa học để phòng trị bệnh đạo ôn, hướng đến một nền nông nghiệp an toàn và bền vững. Nhiều công trình khoa học có giá trị về ứng dụng xạ khuẩn để phòng trị bệnh đạo ôn hại lúa đã được công bố trên các tạp chí trong nước và quốc tế. Tuy nhiên, hầu hết các nghiên cứu về xạ khuẩn được thực hiện trong phòng thí nghiệm, một số nghiên cứu được thực hiện trong nhà lưới và ngoài đồng nhưng chưa có công trình nghiên cứu ứng dụng xạ khuẩn phòng trị bệnh đạo ôn hại lúa trên đất nhiễm mặn.
Chọn chủng xạ khuẩn có khả năng đối kháng nấm P. oryzae
Để giải quyết vấn đề trên, đề tài: Nghiên cứu và ứng dụng xạ khuẩn trong phòng trị bệnh đạo ôn hại lúa do nấm P. oryzae trên vùng đất nhiễm mặn đã được thực hiện nhằm mục tiêu chọn chủng xạ khuẩn có khả năng chịu mặn và đối kháng tốt với nấm P. oryzae trong điều kiện phòng thí nghiệm; nghiên cứu cơ chế đối kháng thông qua khả năng tiết enzyme phân giải chitin và β-1,3-glucan của các chủng xạ khuẩn có triển vọng; định danh các chủng xạ khuẩn có triển vọng đến mức độ loài; đánh giá khả năng phòng trị bệnh đạo ôn của các chủng xạ khuẩn trong điều kiện nhà lưới; đánh giá hiệu quả phòng trị bệnh đạo ôn của các chủng xạ khuẩn chịu mặn được chọn ở điều kiện ngoài đồng.
Bệnh đạo ôn hại lúa và hai chủng xạ khuẩn phòng trị hiệu quả bệnh đạo ôn hại lúa ở vùng đất nhiễm mặn.
Sau thời gian nghiên cứu, đề tài đã chọn được 7 chủng xạ khuẩn: S06-MBL, S09-MBL, S17-MBL, S09-MTV, S03-MST, S18-MCM, S31-MCM có khả năng đối kháng cao với nấm P. oryzae gây bệnh đạo ôn hại lúa trong tổng số 126 chủng xạ khuẩn phân lập từ đất trồng lúa nhiễm mặn ở Đồng bằng sông Cửu Long. Ba chủng xạ khuẩn: S06-MBL, S09-MBL và S17-MBL thể hiện khả năng đối kháng cao với nấm P. oryzae gây bệnh đạo ôn trong môi trường có bổ sung muối NaCl nồng độ 2‰, có khả năng ức chế bào tử nấm bệnh đạo ôn mọc mầm và thể hiện khả năng tiết enzyme chitinase và β-1,3-glucanase cao. Chủng S06-MBL là loài Streptomyces fradiae, chủng S09-MBL là loài Streptomyces bikiniensis và chủng S17-MBL là loài Streptomyces lavendulae. Hai chủng xạ khuẩn S09-MBL và S17-MBL cho hiệu quả giảm bệnh cao tương đương với thuốc hoá học Beam 75WP khi xử lý áo hạt và phun lên lá (mật số 108 cfu/ml) vào 2 ngày trước và 2 ngày sau khi lây bệnh nhân tạo thông qua tỷ lệ bệnh thấp (<4,22%), chỉ số bệnh thấp (<14,8%) và hiệu quả giảm bệnh cao (51,7-76,2%). Hai chủng xạ khuẩn S09-MBL (S. bikiniensis) và S17-MBL (S. lavendulae) khi xử lý kết hợp áo hạt và phun lên lá mật số 108 cfu/ml vào 3 thời điểm 20, 40 và 60 ngày sau sạ có khả năng phòng trị bệnh đạo ôn hại lúa. Bên cạnh đó, hai chủng xạ khuẩn này cũng giúp tăng số lượng hạt chắc/bông và tăng năng suất thực tế ở điều kiện ngoài đồng trên đất nhiễm mặn tại tỉnh Bạc Liêu.
PGS.TS Trần Vũ Phến - Khoa Bảo vệ thực vật (Trường Đại học Cần Thơ) cho biết, bệnh đạo ôn được đánh giá là một dịch hại quan trọng trên lúa và đã có nhiều kết quả nghiên cứu về phòng trừ sinh học bệnh này được công bố, nhưng hầu hết được thực hiện trong môi trường không nhiễm mặn. Nhiều chủng xạ khuẩn có hiệu quả kiểm soát sinh học hiệu quả bệnh đạo ôn lúa đã được xác định, nhưng hiệu quả của chúng trong điều kiện môi trường nhiễm mặn vẫn chưa được làm sáng tỏ. Môi trường phi sinh học thường có ảnh hưởng đến hiệu quả phòng trừ của các tác nhân đối kháng, tuy nhiên có ảnh hưởng như thế nào trong trường hợp bệnh đạo ôn trên lúa gần như vẫn chưa có nghiên cứu nào được công bố… Nghiên cứu của TS Đặng Nguyệt Quế nhằm xác định các chủng xạ khuẩn có thể hoạt động hiệu quả trong quản lý bệnh đạo ôn trên cây lúa canh tác trong môi trường nhiễm mặn là cần thiết và có ý nghĩa thực tiễn trong quản lý dịch bệnh theo quy trình quản lý tổng hợp, mang lại ích lợi thiết thực cho nông dân, góp phần tăng hiệu quả và tính bền vững của sản xuất lúa ở điều kiện nhiễm mặn ở Bạc Liêu, mở ra triển vọng trong điều trị bệnh đạo ôn ở các địa phương vùng Đồng bằng sông Cửu Long.
Ninh Diện